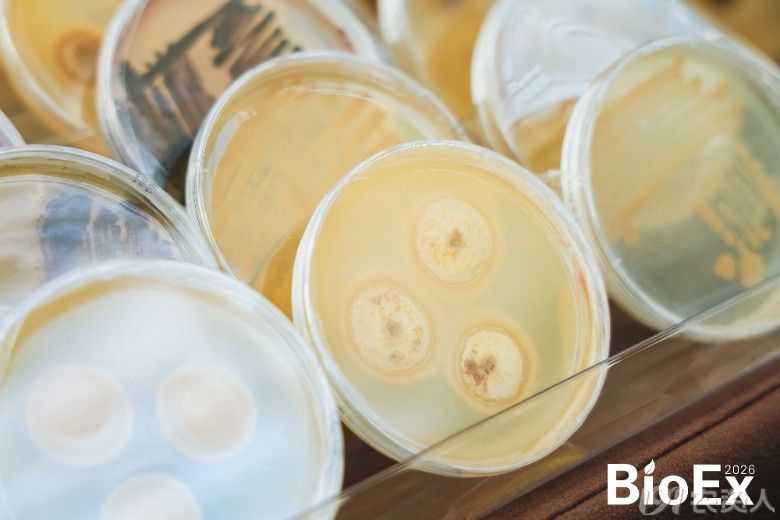

段栌钦总监发表主题演讲|图源:BioEx
2026年是“十五五”规划的开局之年,刚刚发布的中央一号文件明确提出“发展生物科技、生物产业”“加快农业生物制造关键技术创新”,将生物农业提升至培育农业新质生产力的战略高度。与此同时,“生物制造将在‘十五五’迎来黄金发展期”已成为行业共识,生物农药、生物肥料等农业生物制造正从技术储备期迈入产业化爆发期。但在市场端,种植户对产品实效的要求也愈加严苛——以线虫防治为例,尽管化学杀线剂层出不穷,但“防不住”“持效短”“伤根系”等痛点始终未解。
慕恩生物的选择是回归微生物资源本身。成立十年以来,公司已建成全球最大、生物多样性最高的微生物菌种库,保藏自主知识产权菌株超过35万株。从微生物活性保持技术到剂型创新,从功能基因挖掘到产业化放大,慕恩生物正以全链条研发能力,推动生物农业向更高效、更精准的方向加速迭代。

此次亮相的升级版金削线®,正是这一能力的最新注脚。研发团队从35万菌株库中优中选优,锁定性能突出的自主产权菌株——仁诺伯克霍尔德氏菌M222,通过系统的微生物迭代,开辟了一条多机制协同、防控与修复并重的线虫防治新路径。该菌株可释放8种挥发性活性物质,对线虫虫卵抑制率最高达94.47%;田间试验显示根结减退80%以上,土壤线虫基数降低90%。
“我们追求的不仅是防效数字,更是种植户愿意持续使用的解决方案。”段栌钦在演讲中表示,金削线®苗期即可安全使用,一次施用可诱导作物产生持久抗性。在北京西瓜、山东番茄、广西番石榴等产区的多年多点试验中,金削线®展现出稳定的防效与显著的增产作用,采收期延长约15天。

会议现场,慕恩生物还同步展出了微生物种子处理、生物农药、生物肥料等多类农业微生物制剂产品,研发团队与来自多个国家的农化精英展开深度交流,围绕减少农业化学投入依赖、生物制剂产业化链路、微生物技术出海合作等产业前沿发展命题共商共研,以期推动创新性农业微生物解决方案在全球多元农业生产场景的落地与规模化应用。
从2022年首次亮相BioEx,到2025年以哈茨木霉OD技术领跑行业,再到今年推出升级版金削线®,慕恩生物连续五年的参会轨迹,既彰显了企业对农业一线需求的持续深挖,也印证了其技术迭代的硬核实力。作为生物制剂的先行者,慕恩生物始终以微生物资源为支点,持续加码研发投入,不断拓展生物制造的农业应用边界,推动生物制剂从实验室数据转化为田间口碑,为中国生物农业高质量发展提供硬核支撑,为全球农业绿色转型贡献东方智慧。


